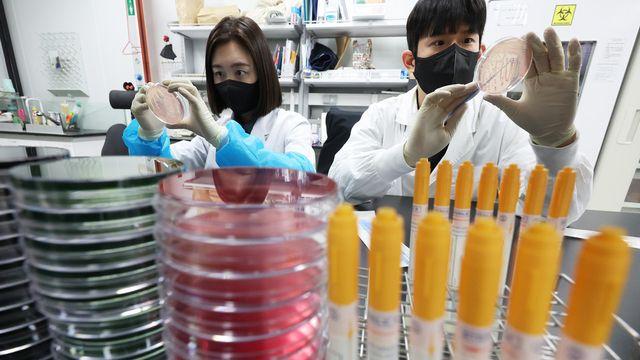
thumbimg

뉴스
- 한미정상회담, 트럼프 체면 살리고 실리 챙기는 길 찾아야
- 비즈니스플러스 2025.08.18
- 이용웅 주필 도널드 트럼프 대통령의 재등장 이후 미국은 전세계를 상대로 관세전쟁을 벌이고
- 삼일PwC, 세계경제학자대회 스폰서 참가
- 이데일리 2025.08.18
- [이데일리 권오석 기자] 삼일PwC가 22일까지 서울 강남구 코엑스에서 열리는 세계경제학자
- 李 대통령 국정 지지율 51.1%...취임 후 최저치
- 아주경제 2025.08.18
- 이재명 대통령과 김혜경 여사가 17일 서울 용산CGV에서 '독립군:끝나지 않은 전쟁' 관람
- 아산시평생학습관, "100세시대 미리 준비하세요"
- 중도일보 2025.08.18
- 아산시 평생학습관이 초고령사회 진입과 기대수명 증가에 따라 성인진로교육 프로그램인 '100
- LG유플러스, 맞춤형 ARS 도입…"대기 시간 66% 단축"
- 아주경제 2025.08.18
- LG유플러스가 고객 편의 향상을 위해 ARS(자동응답시스템) 메뉴 맞춤 제공 서비스를 도입
- "K리그 컬래버 먹거리와 함께 일상에서 K리그 즐기자"…세븐일레븐, 스포츠 마케팅 확대
- 비즈니스플러스 2025.08.18
- 사진=세븐일레븐 편의점 세븐일레븐은 '일상 속 K리그 경험'을 강화한다고 18일 밝혔다.
- "죽은 동물 수 많아"…기르던 파충류 95마리 '미라' 만든 20대
- 이데일리 2025.08.18
- [이데일리 채나연 기자] 다른 지역으로 일하러 떠나면서 집에서 기르던 파충류 수십 마리를
- 아이티센글로벌, 상반기 영업익 554억원…전년 동기 比 178% 증가
- 아주경제 2025.08.18
- 아이티센글로벌 로고 [사진=아이티센글로벌] 아이티센글로벌은 올해 상반기 연결 기이 2조90
- 음식점 위생 불량 사례 속출...서울시, 여름철 음식점 1985곳 집중 점검
- 소비자경제신문 2025.08.18
- 서울시가 여름철 폭염과 폭우로 인한 식중독 발생 위험이 높아지자 시민 안전을 위해 위생
- 스틸리언-현대해상 '맞손'…모의해킹과 사이버보험 시너지 낸다
- 모두서치 2025.08.18
- 사진 = 뉴시스 스틸리언은 현대해상화재보험과 사이버보험 고객 대상 모의해킹 서비스 제공
- 알테오젠 "활성 높인 히알루로니다제 변이체 특허 출원"
- 모두서치 2025.08.18
- 사진 = 뉴시스 바이오 플랫폼 기업 알테오젠은 ‘활용 범위가 확대된 히알루로니다제 변이
- 뉴파워프라즈마, 2분기 매출액 1633억…전년比 15.8%↑
- 모두서치 2025.08.18
- 사진 = 뉴시스 뉴파워프라즈마는 2분기 연결 매출액이 1633억원을 기록해 전년 동기
- LG헬로, 집중호우 피해 충남 태안군 '희망 꾸러미' 전달
- 모두서치 2025.08.18
- 사진 = 뉴시스 LG헬로비전은 최근 집중호우로 큰 피해를 입은 충남 태안군 고남면 지역
- 코윈테크, 2분기 매출 481억…전분기比 82.3%↑
- 모두서치 2025.08.18
- 사진 = 뉴시스 스마트 팩토리 자동화시스템 선도기업 코윈테크는 올해 2분기 매출액이
- 박강수 마포구청장, 역사 위치 변경 1인 시위 릴레이 첫발
- 한국금융신문 2025.08.18
- [한국금융신문 주현태 기자] 박강수 마포구청장은 지난 17일 홍대입구역 인근 ‘레드로드’
- "레드로드 지켜라" 마포구청장, 역사 위치 변경 1인 시위 릴레이 첫발
- 파이낸셜경제 2025.08.18
- ▲ 8월 17일, 유동인구가 가장 많은 홍대입구역 인근에서 1인 피켓 시위를 하는 박강수
- 서울 중구, 225억 기업도약든든펀드 조성
- 파이낸셜경제 2025.08.18
- ▲ 펀드운용사 선정 기념 촬영 [파이낸셜경제=김영란 기자] 서울 중구가 ‘기업하기 좋은 도
- 실질적 채용 연계 성과… 대전 서구 중장년 취업 지원 강화
- 파이낸셜경제 2025.08.18
- ▲ 대전 서구 구직자 만남의 날 행사 [파이낸셜경제=김예빈 기자] 대전 서구는 중장년층 대
- 괴산군, 18~21일 '2025 을지연습' 실시
- 파이낸셜경제 2025.08.18
- ▲ 괴산군, 18~21일 '2025 을지연습' 실시 [파이낸셜경제=김영란 기자] 충북 괴산
- 횡성군, 민생경제 회복을 위한 현장소통
- 파이낸셜경제 2025.08.18
- ▲ 횡성군, 민생경제 회복을 위한 현장소통 [파이낸셜경제=김영란 기자] 횡성군은 지난 16

경기
평택북부장애인복지관, 2025년 장애당사자 제4차 권익옹호교육 마무리
김기보 / 25.11.26